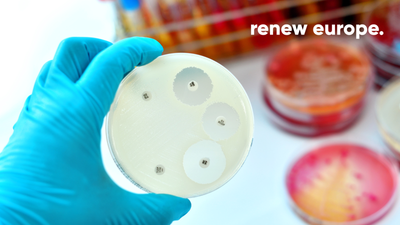
Bacteries

Renew Europe urges EU-wide action to stop antimicrobial resistance

Renew Europe fully supports today's vote in plenary on a parliamentary resolution to fight antimicrobial resistance through EU action. It is estimated that more than 35,000 people in Europe and more than 1.2 million people worldwide die every year as a direct result of infections caused by bacteria, for which the current generation of antibiotics now prove ineffective. With these drug-resistant bacteria still on the rise and effective medical countermeasures lacking, casualties could, by 2050, rise to more than 10 million deaths per year worldwide, which is more than the expected number of casualties from cancer and diabetes combined.
Bearing in mind that antimicrobial resistance not only affects human health, but also that of animals and the environment, more decisive action in a One Health approach will thus be needed to successfully combat antimicrobial infections and attributable deaths.
For Renew Europe, there is an urgent need to roll out a multi-faceted strategy to combat AMR, as the problem is deep-rooted, cross-border and no single member state can solve it alone. It is therefore recommended to raise public awareness of the risk of overuse and to discourage the over-prescription of antibiotics, whether it be for human of animal use, while also starting preventive mechanisms to reduce the incorrect disposal of antimicrobials.
MEP Billy Kelleher, (Fianna Fáil Party, Ireland) Renew Europe shadow rapporteur for the resolution on EU action to combat antimicrobial resistance, said:
“Anti-microbial resistance is a silent but imminent threat to citizens. Member states need to take urgent and decisive action to stop it in tracks. With today’s resolution, the Parliament has expressed a strong and united position calling for better diagnostics, better information sharing, better education and better data. To achieve these goals, we need to ensure that all stakeholders are involved, from scientists to the farmers, from the doctors to our children.”
In addition to the proposals mentioned, Renew Europe also wants more investments to be made in a sustainable innovation climate so that research, development and access to new antimicrobial agents and other medical countermeasures relevant to the fight against AMR can be accelerated.
